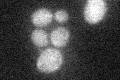
YKL050C
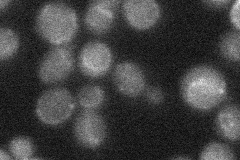
YKL050C
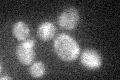
YKL050C
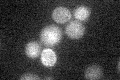
YKL050C

View description
Protein of unknown function; the YKL050W protein is a target of the SCFCdc4 ubiquitin ligase complex and YKL050W transcription is regulated by Azf1p
Localization:
Intensity:
Fold change:
Significance:
-
C’ GFP library in SD
cytosol19.75 -
N' NOP1pr-GFP in SD

cytosol,nucleus78.7696 -
N' TEF2pr-mCherry in SD

nucleus40.7445 -
N' NATIVEpr-GFP in SD
below threshold20.0735 -
N' TEF2pr-VC and Cyto-VN in SD

nucleus32.945 -
C’ GFP library in SD+DTT

cytosol16.530.83No -
C’ GFP library in SD+H2O2
cytosol16.730.84No -
C’ GFP library in Starvation Media
cytosol18.640.94No -
C’ GFP library on the background of Pup2-DaMP

cytosol, cell periphery -
C’ GFP library on the background of CCT mutant

cytosol18.93070.958138No
